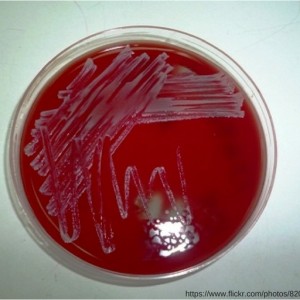
110: Treatment of Coagulase-Negative Staphylococci Infection

A free twice-weekly show where you can listen to critical care and hospital pharmacy information
Subscribe to the #1 ranked critical care and hospital pharmacy podcast, The Elective Rotation here:
116: Lord of the Penicillin (Allergy) Dance
115: Oral vancomycin prophylaxis for C. Diff, fentanyl fluconazole interaction, and a free drug information resource
114: Three Productivity Hacks for Busy Hospital Pharmacists
113: Early vasopressin vs norepinephrine in septic shock, treatments for refractory reactive airway disease, and a resource for Pharmacy Nation
112: Serotonin syndrome from linezolid plus fentanyl and the clinical relevance in critically ill patients
111: PPIs increase the risk and severity of hospital-acquired CDiff, will IV lipids work for liposomal bupivacaine toxicity, and a resource to polish up your CV
110: Treatment of Coagulase-Negative Staphylococci Infection
109: Should high dose heparin be used to prevent VTE in obese patients, do the new quinolone warnings affect ICU patients, and a resource to help apply the new sepsis definitions
108: Treatment of Drug-Induced Torsades
107: Banana Bags in ICU Patients, Should Pharmacists Program And Start IV Pumps, and DailyMed
106: How Pharmacists Can Improve Their Working Relationships With Physicians
- « Previous Page
- 1
- …
- 77
- 78
- 79
- 80
- 81
- …
- 89
- Next Page »